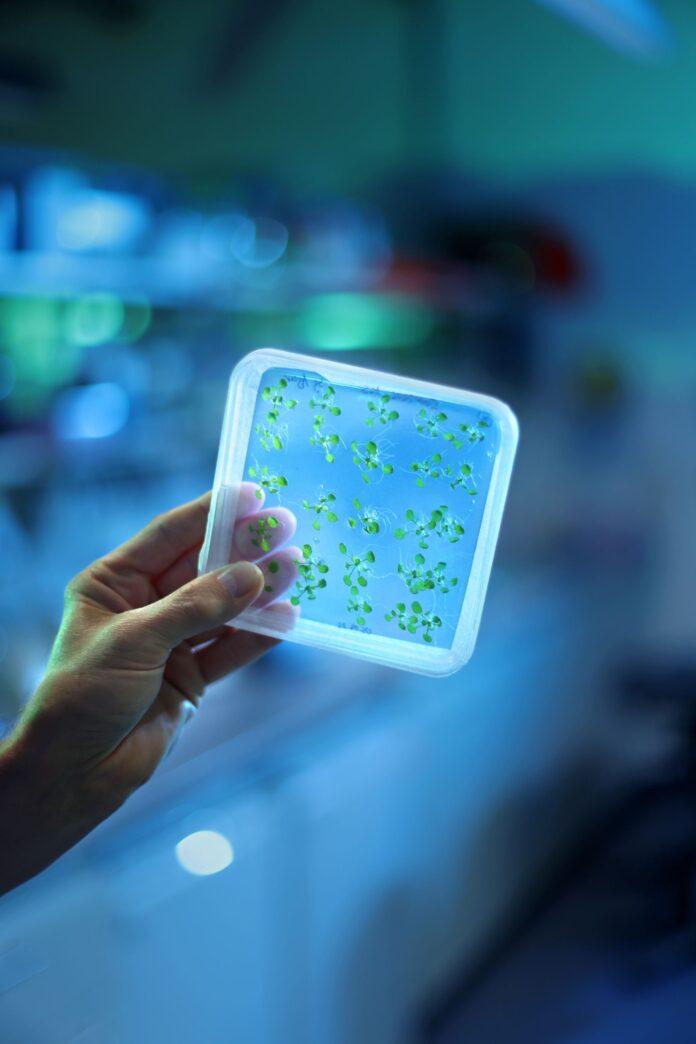

EU fördert das Projekt mit rund 7,5 Millionen Euro.
Brüssel/München (01.12.2025): Ein Forschungsteam unter der Leitung von Dario Leister von der Ludwig-Maximilians-Universität München (LMU) untersucht, wie die Photosynthese effizienter gestaltet werden kann. Pflanzen sollen widerstandsfähiger werden, die Ernährungssicherheit verbessert und sauberere Energiequellen erschlossen werden. Die Europäische Union unterstützt das Projekt durch den Europäischen Forschungsrat mit einem Zuschuss von 7,5 Millionen Euro.
„Die Weltbevölkerung wächst, aber gleichzeitig steht immer weniger Fläche für den Anbau unserer Nahrungsmittel zur Verfügung. Der Klimawandel verschärft die Situation zusätzlich, denn Pflanzen sind heute mehr denn je schwankenden Bedingungen ausgesetzt. Sie müssen physiologisch auf das reagieren, was in ihrer Umgebung geschieht. Diese Reaktionen sind noch nicht gut verstanden und nicht optimal auf unsere Anforderungen an Nutzpflanzen abgestimmt“, erklärt Professor Dario Leister, der das Forschungsteam am Lehrstuhl für Molekularbiologie der Pflanzen der Abteilung Pflanzenwissenschaften der LMU leitet.
„Unsere langfristige Vision ist es, dass der Mensch eine Vielzahl von Nutzpflanzen produzieren kann, die ideal an unterschiedliche, herausfordernde Umgebungen und Bedingungen angepasst sind. Letztlich soll so die Ernährungssicherheit gewährleistet werden. Um dies zu erreichen, müssen wir jedoch zunächst verstehen, wie die Photosynthese – der Motor der Pflanzen – funktioniert und wie sie verbessert und robuster gemacht werden kann“, ergänzt Leister.
Der Wissenschaftler ist von der Photosynthese fasziniert, da mithilfe von Sonnenlicht Wasser gespalten und somit im Prinzip sauberer Wasserstoff erzeugt werden kann. Pflanzen benötigen dafür lediglich reichlich verfügbare Grundstoffe und einige Mikroelemente. Im Vergleich zu dieser sauberen, kostengünstigen und maximal nachhaltigen Lösung sind menschengemachte technische Alternativen sehr aufwendig, teuer und wenig nachhaltig. Das Team untersucht daher, wie Organismen Sonnenlicht in nutzbare Energie umwandeln – und wie Menschen von ihnen lernen können, diesen Prozess effizienter zu gestalten.
Das LMU-Team nutzt winzige, schnell wachsende Mikroorganismen wie Cyanobakterien und Grünalgen, um zu erforschen, wie sich die Photosynthese unter Stressbedingungen wie schwankender Lichtintensität oder Hitze anpasst. Diese Erkenntnisse könnten dazu beitragen, Pflanzen zu züchten, die besser mit den Folgen des Klimawandels umgehen können. Dadurch würden Ernährungssicherheit und Nachhaltigkeit gesteigert. Für das Team geht es bei der Erforschung der Photosynthese nicht nur um Pflanzen, sondern auch darum, die Grundlagen dieses sauerstoffproduzierenden Prozesses zu verstehen und von der Natur inspirierte Lösungen für die Zukunft zu entwickeln.
Das Münchner Team arbeitet dabei eng mit Neil Hunter von der Universität Sheffield sowie Josef Komenda vom Institut für Mikrobiologie der Tschechischen Akademie der Wissenschaften zusammen. „Pflanzen können derzeit nur etwa die Hälfte des Sonnenlichts nutzen. Deshalb entwickeln wir neue Ansätze, um ihre Fähigkeit zur Absorption und Umwandlung von Licht zu verbessern. Eine effizientere Photosynthese führt zu ertragreicheren Nutzpflanzen. Das bedeutet, dass man mit der gleichen Energiemenge mehr erreichen kann“, beschreibt Leister die gemeinsame Vision.
Mit der finanziellen Unterstützung des Europäischen Forschungsrats in Höhe von 7,5 Millionen Euro wollen die Wissenschaftler diese Vision nun in die Praxis umsetzen. Die EU-Förderung umfasst auch die Bereitstellung wichtiger Laborausstattung sowie die Finanzierung der Ausbildung von Doktorandinnen, Doktoranden und Postdoktoranden.
Laut Professor Leister ist die EU-Förderung die einzige Möglichkeit, Forschung dieser Größenordnung und Tragweite zu betreiben. „Ich halte sie für unverzichtbar, um bahnbrechende wissenschaftliche Entdeckungen zu erzielen. Ohne diese Zuschüsse würde Europa ins Hintertreffen geraten. Wenn man global wettbewerbsfähig sein will, braucht man solche EU-Fördermittel“, betont er.
Horizon Europe ist das wichtigste Förderprogramm der EU für Forschung und Innovation. Das Budget für den Zeitraum 2021-2027 beträgt 93,5 Milliarden Euro. Seit Beginn der EU-Forschungs- und Innovationsprogramme hat Deutschland über 30 Milliarden Euro an Fördermitteln erhalten. Bereits seit über 40 Jahren unterstützt die EU Forschung und fördert Innovation sowie internationale Zusammenarbeit. Von Durchbrüchen in den Neurowissenschaften und der Architektur bis hin zur Erdbeobachtung und sauberer Luftfahrt reichen die Aktivitäten der EU weit über das Labor hinaus.
Hinweis für Journalisten:
Weitere Informationen finden Sie auf der Science4EU-Website, wo Sie Beispiele dafür finden, wie die EU Wissenschaftler, Forscher und Innovatoren – einschließlich des Forschungsteams der LMU – dabei unterstützt, die Grenzen des Wissens zu erweitern.
Interviewanfragen an Professor Leister können per E-Mail an folgende Kontakte gerichtet werden:
Pressekontakt Science4EU:
KaiserCommunication GmbH, Guntram Kaiser, Haus der Bundespressekonferenz, Zimmer 2408, Schiffbauerdamm 40
Mobil: +49 (172) 242 74 77
E-Mail: kaiser@kaisercommunication.de
Pressestelle LMU:
Claudia Russo, Leitung Presse und Kommunikation
Ludwig-Maximilians-Universität München (LMU),
Telefon: +49 (0) 89 2180-3423
E-Mail: presse@lmu.de
Die KaiserCommunication GmbH betreut inländische und internationale Kunden aus den verschiedensten Bereichen.
Firmenkontakt
KaiserCommunication GmbH
Guntram Kaiser
PSF 610365
10926 Berlin
030-84520000
www.kaisercommunication.de
Pressekontakt
KaiserCommunication GmbH
Guntram Kaiser
Postfach 610365
10926 Berlin
030-84520000
www.kaisercommunication.de
Bildquelle: European Union 2025